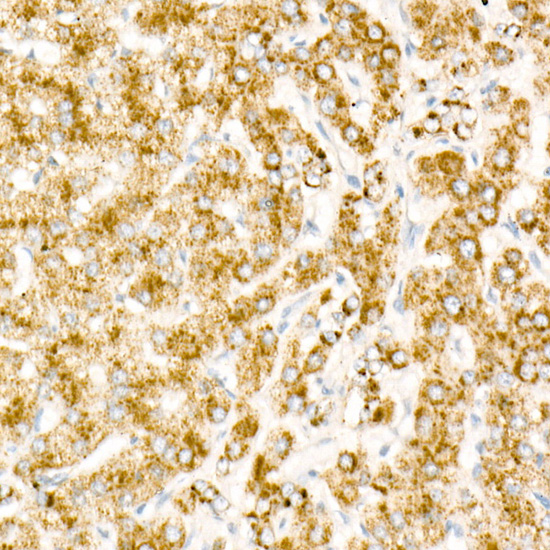

Goat Anti-Mouse IgG2a Antibody (HRP)
A93382
ApplicationsWestern Blot, ELISA
Product group Antibodies
ReactivityMouse
Overview
- SupplierAntibodies.com
- Product NameGoat Anti-Mouse IgG2a Antibody (HRP)
- Delivery Days Customer7
- ApplicationsWestern Blot, ELISA
- CertificationResearch Use Only
- ClonalityPolyclonal
- ConjugateHRP
- HostGoat
- IsotypeIgG
- Scientific DescriptionGoat Anti-Mouse IgG2a Antibody (HRP).
- ReactivityMouse
- UNSPSC12352203